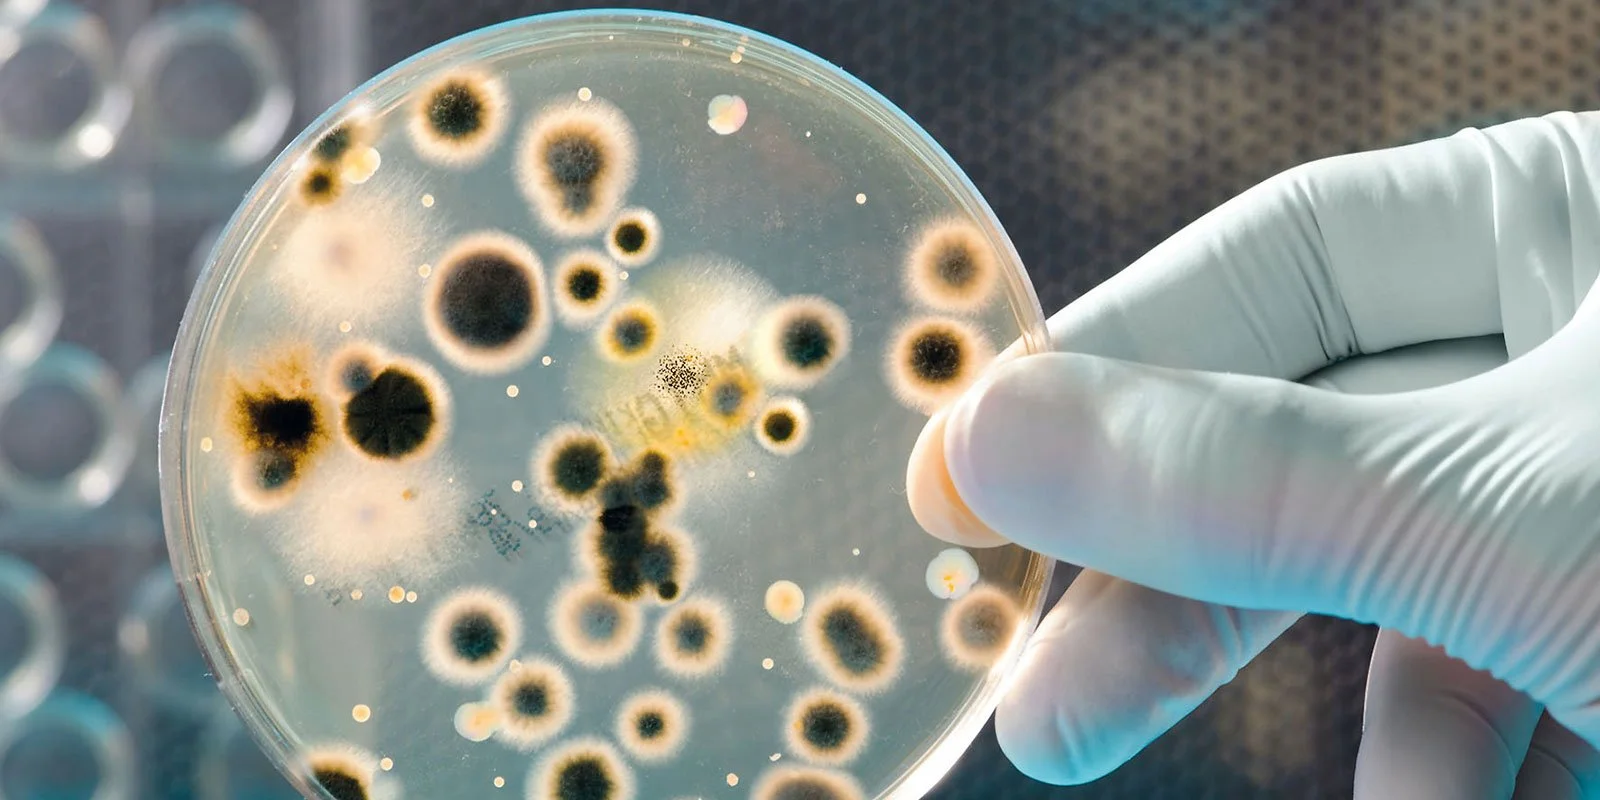
A review to remember | Introduction of electrolysed water

Jardin Tan
We’re happy to announce that eWater Systems has now been installed in Jardin Tan, Shannon Bennett’s latest project. The inclusion of Jardin Tan marks the sixth collaboration between Vue de Monde Group and eWater Systems...
A review to remember | Introduction of electrolysed water
Food safety has become and continues to be the number one public concern. Considerable progress to strengthen food safety systems has been achieved in many countries. However...
eWater now proudly flowing at The Shrine of Remembrance
An eWater System has been installed as part of Melbourne’s recently completed redevelopment of the Visitors Centre at Melbourne’s` Shrine of Remembrance...